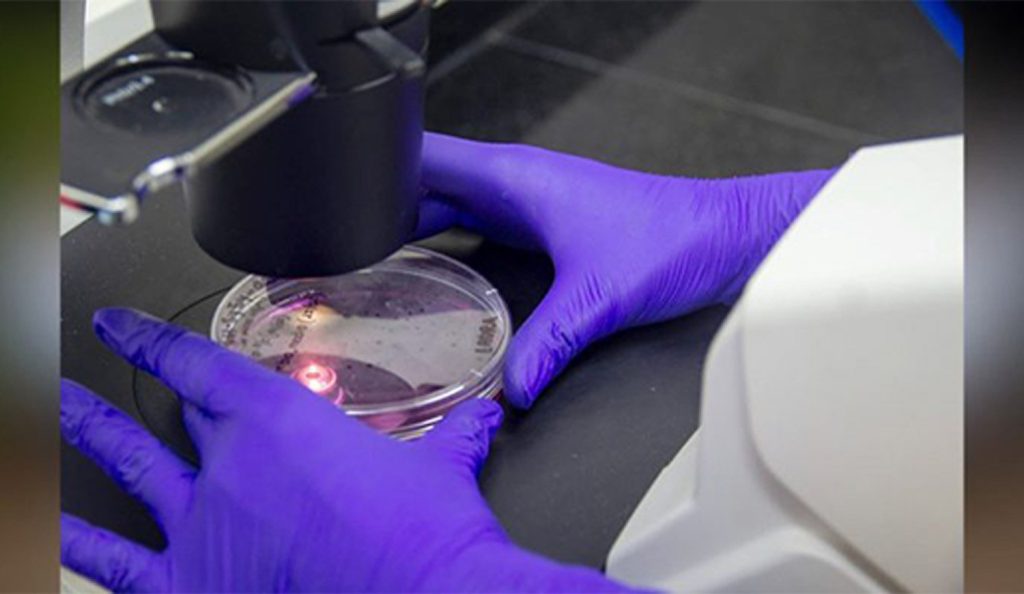

Científicos argentinos patentan una nueva molécula para combatir el Parkinson
Investigadores del Conicet, de la Universidad Nacional de Tucumán (UNT) y de la Universidad de Buenos Aires (UBA), con la colaboración de una empresa de biotecnológica norteamericana, desarrollaron una nueva molécula que demostró, mediante ensayos preclínicos, una mejora de los síntomas característicos de la enfermedad de Parkinson y una importante actividad neuroprotectora. Se trata de Pegasus o DAD 9, que es la primera molécula capaz de abordar los dos principales problemas de la enfermedad de Parkinson: mejorar los síntomas y evitar la progresión de los daños neuronales. El compuesto es un candidato a fármaco que consiguió superar la etapa preclínica. “Hace 10 años venimos desarrollando estudios sobre las bases moleculares de la enfermedad de Parkinson, justamente porque entendiendo qué es lo que produce la enfermedad, qué es lo que mata a las neuronas dopaminérgicas en la patología, uno puede encontrar cómo proteger esas neuronas o cómo inhibir el daño neuronal”, expresó Rosana Chehín, directora del Instituto de Medicina Molecular y Celular Aplicada de la UTN.
Fuente: Diario Hoy (La Plata)






